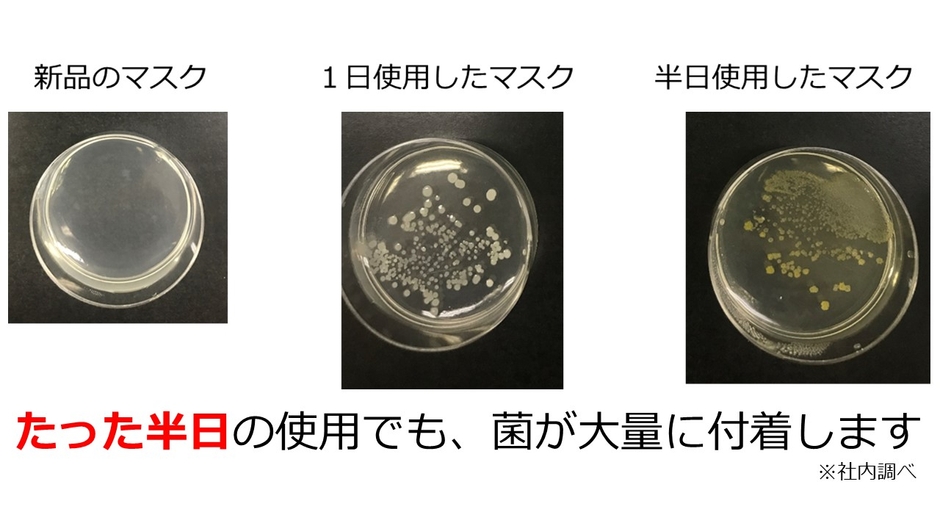
マスクに付着の菌について　ポケスター

〜不織布マスクや小物をどこでも除菌習慣 〜
『UV-C』×『高反射特殊アルミシートLUXAL®』で、 菌やウイルスをたったの2分で徹底除菌!
東洋アルミエコープロダクツ株式会社(本社:⼤阪府⼤阪市 代表取締役社⻑:⼭⼝正起)は、UV-Cを効果的に照射する、携帯型除菌ケース「ポケスター®2.0」の『Makuake』応援購入プロジェクトを2022年3月28日(月)より開始いたします。

商品特長
①照射されたUV-Cをケース内面の高反射特殊アルミシートLUXAL®が乱反射するので、収容物全体にUV-Cが素早く届き、たったの2分で生菌減少率99%を実現します

② 特殊アルミシートLUXAL® がケース内でUV-C光を高効率に反射するのでムラなく除菌します
・UV-Cは直射日光にも含まれている波長350nmの紫外放射の約1,600倍もの殺菌力を有し、有害なウイルスも死滅させるという報告もあります。
・LUXAL®は減衰し易い波長260nm帯の紫外線殺菌光UV-Cを高効率に反射

③ ポケットや鞄に入りやすいポータブルサイズ。スタイリッシュなデザインで持ち出して何処でも除菌可能

④利用シーンと除菌対象物


ご存知ですか?マスクは半日でもかなり汚染されています
不織布マスクのプラスチックゴミを減らすことにも繋がる
不織布マスクは素材の殆どがプラスチック樹脂製。毎日使い捨てていた不織布マスクを除菌して長持ちさせれば、廃棄されるプラスチックゴミの削減に繋がります。
「ポケスター2.0」製品概要
●LED:定格出力2mW 260~280㎜×2灯
●素材:本体ABS樹脂
●電源:単3電池2本(別売り。ニッケル水素電池推奨) 乾電池の持続性:約3か月(2分/回x3回/日稼働させるとして試算)
●製品サイズ:約190mm(W)×74mm(L)×23mm(H) (収容部:約180mm(W)×:42mm(L)×15mm(H)
●入数: 1個
●価格:オープン価格(推奨本体価格4,980円)
●販売方法:Makuakeにて応援購入プロジェクトを開始、3月28日(月)より下記URLにてご覧いただけます。
https://www.makuake.com/project/pokester2















